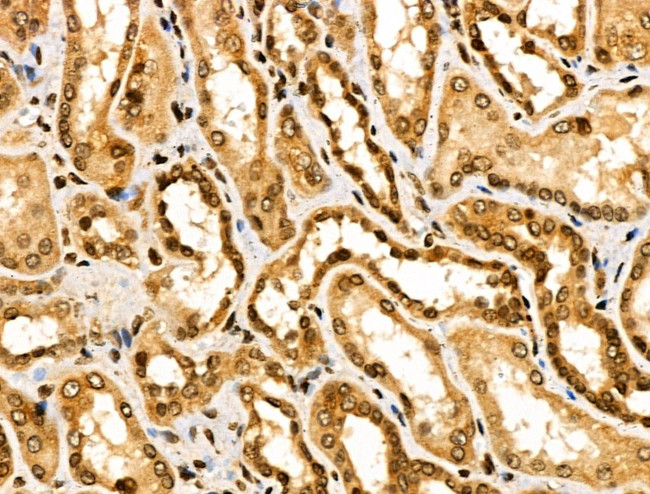
ASC1 Antibody in Immunohistochemistry (Paraffin) (IHC (P))

Search
Invitrogen
ASC1 Polyclonal Antibody
{{$productOrderCtrl.translations['antibody.pdp.commerceCard.promotion.promotions']}}
{{$productOrderCtrl.translations['antibody.pdp.commerceCard.promotion.viewpromo']}}
{{$productOrderCtrl.translations['antibody.pdp.commerceCard.promotion.promocode']}}: {{promo.promoCode}} {{promo.promoTitle}} {{promo.promoDescription}}. {{$productOrderCtrl.translations['antibody.pdp.commerceCard.promotion.learnmore']}}
图: 1 / 8
ASC1 Antibody (PA5-101174) in IHC (P)








产品信息
PA5-101174
种属反应
宿主/亚型
分类
类型
抗原
偶联物
形式
浓度
规格
纯化类型
保存液
内含物
保存条件
运输条件
RRID
产品详细信息
Antibody detects endogenous levels of total TRIP4.
靶标信息
Transcription coactivator of nuclear receptors which functions in conjunction with CBP-p300 and SRC-1 and may play an important role in establishing distinct coactivator complexes under different cellular conditions. Plays a pivotal role in the transactivation of NF-kappa-B, SRF and AP1. Acts as a mediator of transrepression between nuclear receptor and either AP1 or NF-kappa-B. Plays a role in androgen receptor transactivation and in testicular function.
仅用于科研。不用于诊断过程。未经明确授权不得转售。
篇参考文献 (0)
生物信息学
蛋白别名: Activating signal cointegrator 1; ASC-1; Thyroid receptor-interacting protein 4; TR-interacting protein 4; transcription coactivator Asc1; TRIP-4; unnamed protein product; zinc finger, C2HC5-type
基因别名: 4930558E03Rik; ASC-1; ASC1; BB191711; HsT17391; MDCDC; RQT4; SMABF1; TRIP4; ZC2HC5
UniProt ID: (Human) Q15650, (Mouse) Q9QXN3
Entrez Gene ID: (Human) 9325, (Rat) 315769, (Mouse) 56404